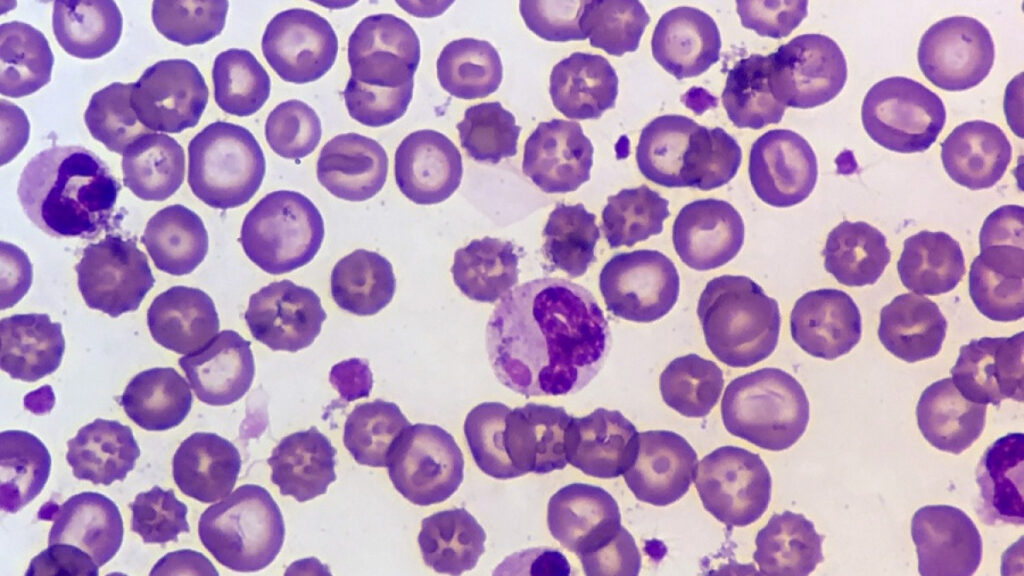
Inductores de crecimiento

El crecimiento y la reproducción de las células precursoras, un aspecto central en el proceso de desarrollo celular, están minuciosamente regulados por una serie de factores, entre los cuales las proteínas denominadas inductores del crecimiento desempeñan un papel fundamental. Estos inductores del crecimiento actúan como señales moleculares que dirigen y coordinan la proliferación celular, facilitando así la generación de una amplia gama de tipos celulares especializados. En este contexto, se han identificado al menos cuatro inductores principales del crecimiento, cada uno con propiedades únicas. Uno de estos inductores, conocido como interleucina 3, sobresale al estimular el crecimiento y la reproducción de casi todas las variedades de células precursoras comprometidas, mientras que los otros están diseñados para inducir el crecimiento de tipos celulares específicos.
Los inductores del crecimiento, mediante la transmisión de señales intracelulares, regulan los procesos clave que impulsan la proliferación celular, como la activación de vías de señalización y la expresión génica. Uno de los inductores más destacados en este contexto es la interleucina 3, una molécula señalizadora que favorece el crecimiento y la división celular en una amplia gama de células precursoras comprometidas. Su efecto promotor en la proliferación celular es diverso y abarca múltiples líneas celulares, lo que lo convierte en un regulador central en el mantenimiento de la población de células precursoras.
En contraste con la interleucina 3, otros inductores del crecimiento tienen una selectividad más definida en sus efectos. Estos inductores están específicamente diseñados para influir en tipos celulares particulares, lo que refleja la especialización y el ajuste preciso requerido en el proceso de diferenciación celular. A través de esta selectividad, el desarrollo de diferentes tipos de células se coordina y controla de manera específica, asegurando la formación equilibrada y funcional de diversos tipos celulares en el organismo.
Recordemos entonces que los inductores del crecimiento desempeñan un papel vital en la regulación del crecimiento y la reproducción de las células precursoras comprometidas durante la hematopoyesis y otros procesos de desarrollo. Entre ellos, la interleucina 3 se destaca por su influencia en la mayoría de los tipos celulares, mientras que otros inductores tienen efectos más específicos. Esta regulación finamente sintonizada garantiza la producción adecuada y coordinada de diferentes tipos celulares, contribuyendo así a la homeostasis y funcionalidad del organismo multicelular.